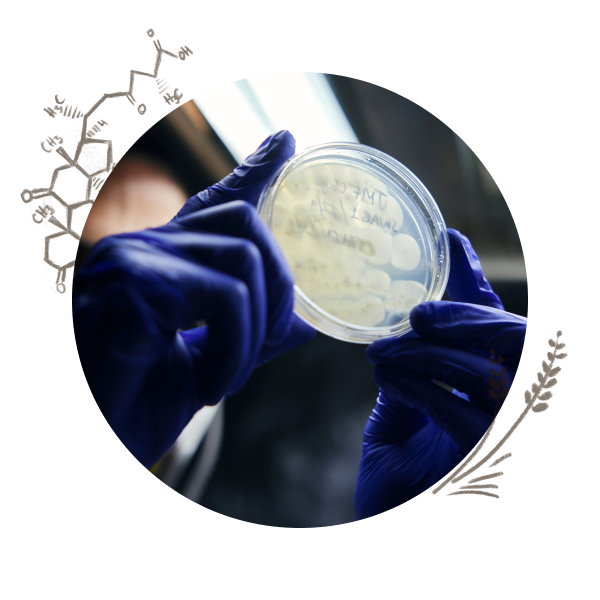

Tag @bristolfungarium to be featured
DISCOVER THE HEALING POWER OF UK-NATIVE MUSHROOMS

Oysters have been prized for centuries for their nutritional value and delicious taste, with large amounts of the essential vitamin ergothioneine. In Traditional Chinese Medicine, oyster mushrooms are recommended for the relaxation of muscles, joints and tendons, to strengthen circulation, and to increase kidney function.
Maitake contains polysaccharides that stimulate the immune system, stabilise blood pressure & sugars, and neutralise free radicals - which also helps with hormone balance, especially in women. Maitake has a high vitamin D content and is rich in vitamins B1 & B2 which assist in regulating the nervous system.
Shiitake are particularly high in vitamin D due to their high ergosterol content and rich in beneficial polysaccharides, minerals, and proteins. This makes this fungi great for skin conditions such as psoriasis and eczema. Shiitake was first used for nutrition and healing in Japan and China where it is also seen as a symbol of youthfulness and virility.

OUR PROCESS